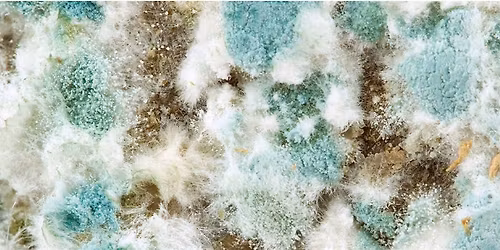
Mold Prevention, Assessment, and Remediation - Training, Tips, and Tools

Advertisement
Information sessions are required for program admission. You must have a student ID number to register and receive attendance credit.About this Event
General information sessions are required for nursing program applicants at Augusta Technical College. This includes students applying to the Practical Nursing, Associate Degree Nursing, and LPN-RN Bridge porgrams. You must have a current student identification number to receive credit for attending this session.
Advertisement
Event Venue & Nearby Stays
Piedmont Summerville Professional Center, 2258 Wrightsboro Road, Augusta, United States
Tickets
USD 0.00
Concerts, fests, parties, meetups - all the happenings, one place.